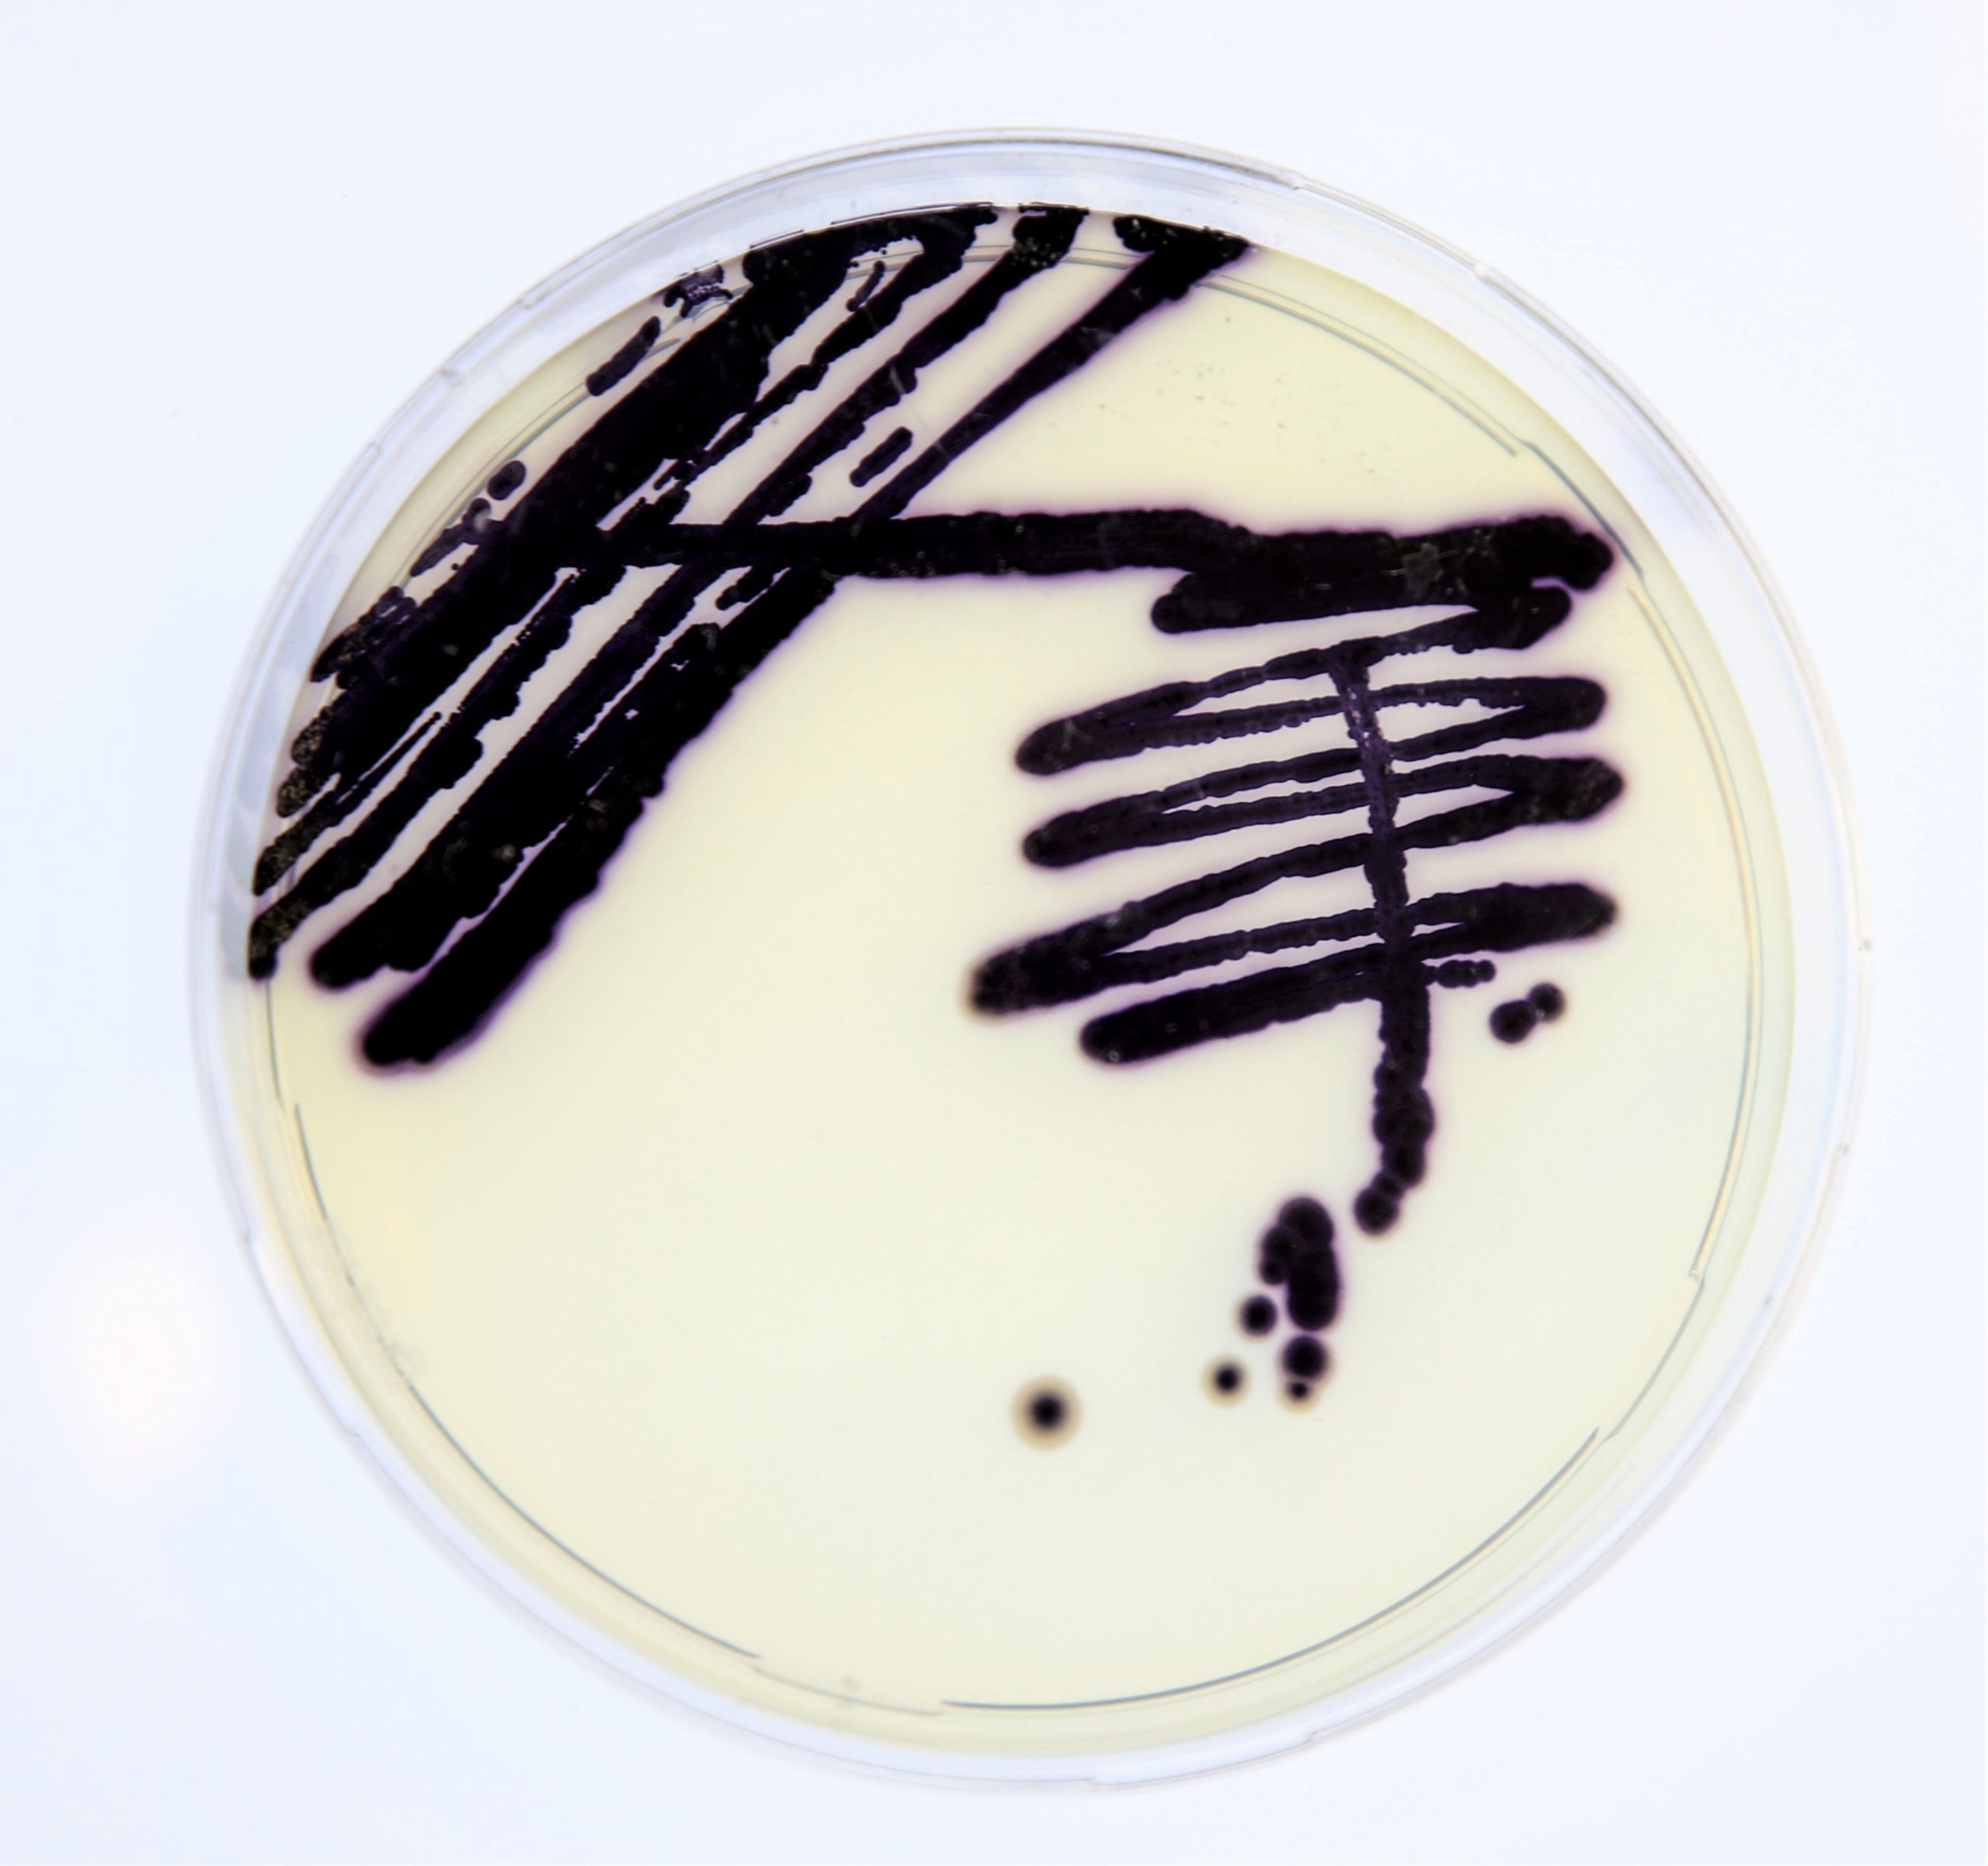

Category Start-ups


Start-up of The Day: ReVibe Energy generates power out of thin air

EU wants €20 billion extra for the Horizon innovation fund, but will it happen?

Start-up of the day: Energy Floors is making smart parking spaces in Rotterdam
Start-up of the Day: Vienna Textile Lab dyes fabrics with bacteria

Start-up of the Day: only f**king perfect vegetables are good enough for the best restaurants

Start-up of the week: a Dutch solution for a Dutch problem

Slush Helsinki is filled with entrepreneurs, researchers and investors, but hardly any politicians

Start-up of the Day: Skinive develops AI-powered app for skin self-examination

